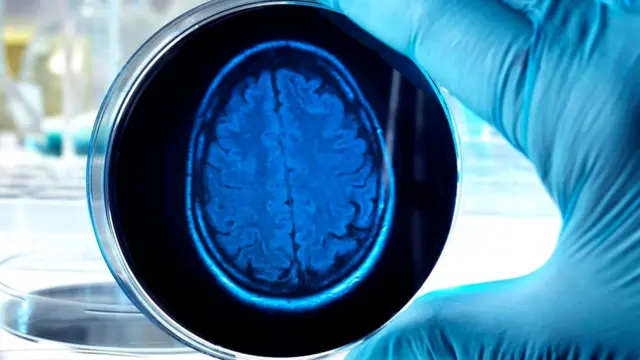
Крошечный мозг не способен мыслить: ему не хватает тела, которое помогло бы ему обрабатывать информацию

Как и зачем ученые выращивают человеческий мозг

Автор фото, iStock
- Автор, Зарайя Горветт
- Место работы, BBC Future
В лаборатории Мадлен Ланкастер в настоящее время находится 300 единиц человеческого мозга. Эти мозги растут отдельно от тела. Обозреватель BBC Future рассказывает, как это происходит.
Во время разговора со мной Ланкастер не убирает руку с живота. Она беременна.
"О, сейчас им около шести-семи месяцев", - говорит она. Их размер не превышает четырех миллиметров. У нее их несколько сотен, и каждый из них уже обзавелся двумя миллионами нейронов.
Конечно, она говорит не об огромном выводке еще нерожденных детей, сама Мадлен ждет обычного ребенка. Ланкастер описывает партию растущих человеческих мозгов, которые были созданы ею в процессе научной работы.
Мы находимся в новом научно-экспериментальном центре молекулярной биологии британского Совета по исследованиям в области медицины в Кембридже.
Он состоит из множества лабораторий со стеклянными стенами, оснащенных самым современным оборудованием. Кажется, что его коридоры растянулись на километры.
Центр не засекречен и не находится под землей, но в этом здании стоимостью 212 млн фунтов осуществляются футуристичные проекты, каждый из которых мог бы лечь в основу сюжета какого-нибудь голливудского фильма.

Автор фото, Zaria Gorvett
Команда ученых во главе с Ланкастер работает над невероятной задачей. На первый взгляд кажется, что она имеет отношение скорее к волшебству, чем к науке: они пытаются превратить в мозг человеческую кожу.
"Этот мозг развивается точно так же, как и у эмбрионов", - утверждает Ланкастер.
Возможно, это и так, но происходит совершенно в другой обстановке. Мозг растет не в утробе матери и не в теле эмбриона, а в гигантском инкубаторе.
Ввиду отсутствия притока крови питательные вещества он получает из специальной жидкости, которую меняют раз в несколько дней.
И, конечно же, у него нет иммунной системы: абсолютно все, что с ним контактирует, необходимо дезинфицировать спиртом.
Когда Ланкастер открывает дверь инкубатора, вопреки моим ожиданиям, его содержимое не производит на меня особого впечатления. Я вижу бесцветные водянистые комочки, плавающие в бледно-розовой жидкости.
Они больше похожи на кусочки размокшего попкорна, чем на источник интеллектуальных способностей.
Но их внешний вид обманчив. На самом деле эти комочки, названные "мозговыми органоидами", очень похожи на мозг обычного человека.
Как и любой другой мозг, органоид имеет серое вещество, состоящее из нейронов, и белое вещество, состоящее из отростков нервных клеток, покрытых жировой тканью.

Автор фото, Zaria Gorvett
Как и обычный мозг, все они состоят из определенных участков - сморщенной коры (считается, что она отвечает за речь и сознательное мышление), гиппокампа (центра эмоций и памяти), мозжечка, координирующего деятельность мышц, и многих других.
В целом их можно считать эквивалентными мозгу девятинедельного плода.
Так как же их удалось создать?
На самом деле создать мозг не так сложно, как кажется. Если у вас есть несколько простых ингредиентов и готовность без конца протирать все спиртом, вы тоже сможете вырастить миниатюрный мозг за несколько месяцев.
Прежде всего вам понадобятся клетки. Ланкастер и ее коллеги взяли их из образцов донорской кожи.
Однако, как ни странно, чтобы создать этот шедевр человеческой эволюции, можно начать с клеток любого типа, независимо от того, где они находятся - в носу, печени или ногтях.
В любые ткани человеческого тела способны превращаться только стволовые клетки, поэтому следующим шагом станет превращение ваших клеток в стволовые.
Для этого ученые использовали своего рода сыворотку молодости клеток - белковый коктейль, способный повернуть время вспять и вернуть любую клетку в ее первоначальное состояние.
Автор фото, iStock
Через неделю у вас образуется пласт клеток, который можно будет извлечь из чашки Петри, а затем сформировать из него шарик.
Ланкастер достает емкость с розовой жидкостью. "Сейчас они крошечные, но разглядеть их можно", - говорит она.
И действительно, в каждой лунке видны едва различимые белые точки. "Они как бы пытаются стать эмбрионом", - поясняет она.
Впоследствии начнется процесс дифференциации стволовых клеток, и однородные шарики превратятся в набор различных клеток. Среди них будут и клетки мозга.
Стоит отметить, что исследователи, как заботливые родители, хорошо кормят свои эмбрионы и всячески способствуют их росту. Но это длится недолго.
Затем шарики из клеток помещают в другую емкость, на этот раз с небольшим количеством питательных веществ. Клетки начинают голодать, и многие из них умирают.
Выживают только клетки мозга. "Они очень стойкие, но никто не знает, почему", - говорит она.
Наконец, развивающийся мозг помещают в желе. "Это необычное желе - сначала оно находится в жидком состоянии, а по мере нагревания в инкубаторе начинает загустевать", - объясняет она.
Желе имитирует ткань, окружающую мозг человеческого эмбриона, заменяя собой череп, и позволяет мозгу развиваться относительно нормально.
Теперь остается только ждать. Через три месяца мы получаем мозг диаметром около четырех миллиметров, содержащий около двух миллионов нейронов.
"Полностью развитый мозг взрослой мыши содержит всего четыре миллиона нейронов, поэтому для нашего исследования двух более чем достаточно", - говорит Ланкастер.
В мозгу не угасает электрическая активность: нейроны постоянно обмениваются сигналами. Ланкастер говорит, что это не такое уж большое достижение с ее стороны.
"В этом нет ничего особенного - просто мы можем убедиться в том, что создали функционирующие нейроны, исполняющие свое предназначение", - поясняет она.
Она сравнивает эти клетки с клетками сердечной мышцы, которые ученым удалось заставить сокращаться в чашке Петри еще в 2013 году.
В отличие от сердечных клеток, запрограммированных перекачивать кровь, нейроны стремятся передавать электрические импульсы.
"Даже если в чашке будет только один нейрон, и ему некому будет отправлять импульсы, это стремление настолько велико, что он будет посылать их сам себе", - говорит Ланкастер.

Автор фото, iStock
В настоящий момент мозг, созданный Ланкастер, не способен думать, однако это и не входило в ее планы.
Пока достоверно не известно, как в нашем мозгу рождаются мысли. Как ни странно, но дать четкое определение понятию "мысль" пока также не удалось.
Тем не менее этот процесс может происходить примерно так. Как правило, получая стимулы из внешнего мира (запахи, звуки, идеи), мозг сохраняет информацию, укрепляя связи между нейронами или формируя новые нейроны.
У среднестатистического человека их около тысячи триллионов, и это означает, что мощность нашего мозга равна мощности компьютера, способного обрабатывать триллион бит в секунду.
Но вот в чем загвоздка: даже имея структуру, схожую с обычным мозгом, искусственно созданный мозг не может нормально развиваться без тела, которое снабжало бы его информацией об окружающем мире.
"Нейроны функционируют, но связи между ними практически отсутствуют", - говорит Ланкастер.
Объяснить это можно на примере человека, родившегося слепым. "Он не видит света, и поэтому участок мозга, отвечающий за обработку соответствующих сигналов, просто не сформируется", - поясняет она.
Подключив искусственно выращенный мозг к электроэнцефалографу, вы, скорее всего, не получите никаких результатов.
Так называемые мозговые волны, которые способен регистрировать этот аппарат, появляются при одновременном возбуждении миллионов нейронов, и их суммарную электрическую активность можно измерить, приложив к коже головы специальные электроды.
"Мне кажется, это полезный опыт. Я была бы сумасшедшей, если бы считала, что в них сформируется полноценная нейронная сеть", - говорит она.
Но Ланкастер и не планировала создать мозг, способный сознательно мыслить. Он нужен ей, чтобы разгадать давнюю загадку: несмотря на наше интеллектуальное превосходство, генетически мы отличаемся от шимпанзе всего на 1,2%.
Это всего лишь в 12 раз больше генетической разницы между отдельными людьми (0,1%). Почему?

Автор фото, iStock
Чтобы выяснить это, ученые заменяли отдельные гены, отвечающие за развитие мозга, генами шимпанзе, а затем использовали полученные клетки для создания гибрида мозга человека и шимпанзе.
По мере его развития проясняется роль каждого гена, и мозг с генами шимпанзе, к примеру, может быть существенно меньше, чем обычный человеческий мозг, либо может содержать меньше нейронов.
Другими словами, этот мозг позволяет ученым проводить эксперименты, которые в ином случае им никогда не разрешили бы осуществить (представьте себе, какой резонанс вызвало бы внедрение генов шимпанзе в мозг живого человека).
В будущем Ланкастер надеется организовать серию экспериментов с мозгом шимпанзе, выращенным в лабораторных условиях.
Это будет непросто, потому что этот вид является охраняемым, и нельзя просто так войти в клетку к шимпанзе и взять у него кусочек кожи. Тем не менее они нашли пусть и не самый привлекательный, но вполне подходящий источник клеток.
"Когда животное в зоопарке приносит потомство, плаценту обычно просто выбрасывают, но мы можем забрать ее себе", - объясняет Ланкастер.
Другие ученые используют органоиды для изучения болезней, характерных только для человека, в том числе аутизма и шизофрении. Ранее исследовать их причины в лаборатории было непросто, ведь они не встречаются у животных.
Возьмем, например, аутизм. Дети, страдающие тяжелой формой этого заболевания, не могут говорить. Как же можно изучить это расстройство на мышах?
Сравнивая мозг, выращенный из клеток кожи здоровых взрослых и пациентов, страдающих аутизмом, в прошлом году ученые смогли доказать, что это заболевание может быть вызвано нарушением баланса между двумя основными типами нейронов - возбуждающими, то есть генерирующими сигналы, и тормозящими - оказывающими обратное действие.
"В здоровом мозгу работа этих двух видов нейронов очень четко скоординирована и оказывает огромное влияние на функционирование всей системы", - говорит Ланкастер.

Автор фото, iStock
Настоящим прорывом стало открытие, что с помощью искусственно выращенного мозга можно не только воспроизвести это расстройство, но и вернуться в прошлое и понять, чем отличается мозг человека, страдающего аутизмом.
"Можно наблюдать за процессом его развития и обнаружить, на каком этапе появляются отличия. В обычных условиях это сделать невозможно", - говорит она.
Мозг, созданный в лаборатории, уже изменил наши представления об этом органе, его заболеваниях и о том, что отличает человека от всех других видов.
Несмотря на то, что впервые создать его удалось лишь в 2013 году, поиск в Google по ключевым словам "мозговые органоиды" уже выдает 2820 научных исследований.
Так что же ждет нас в будущем? Несколько групп ученых работают над совершенствованием мозга, снабжая его кровью, чтобы он мог достичь больших размеров.
В настоящее время мозг размером 4 мм полностью зависит от кислорода и питательных веществ, поступающих в него из окружающей его жидкости.
Для многих ученых конечной целью является создание мозга, который функционировал бы как обычный человеческий - с сетями нейронов, и который можно было бы обрабатывать любыми веществами, резать и изучать, как мозг лабораторных мышей.
Но пока органоиды инертны, как кусочки попкорна, на которые они похожи.
Прочитать оригинал этой статьи на английском языке можно на сайте BBC Future.



















